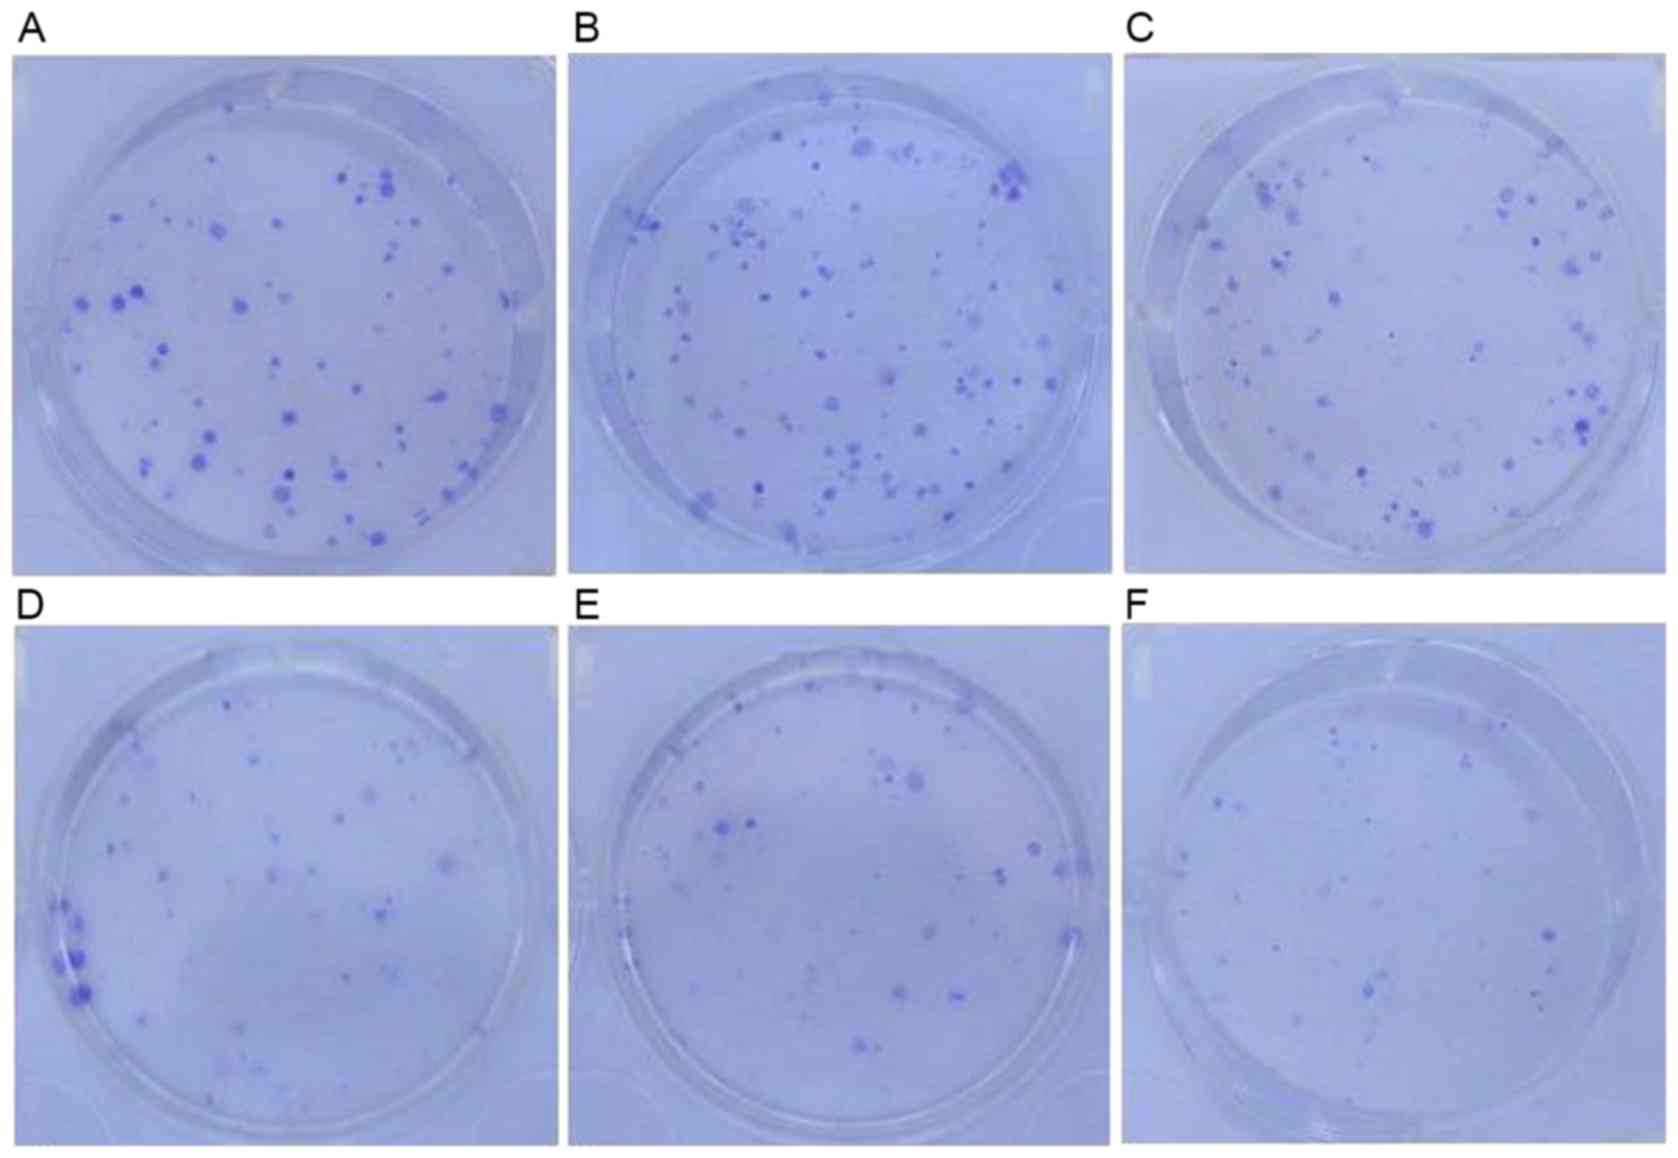

|
1
|
Shao C, Lu C, Chen L, Koty PP, Cobos E and
Gao W: p53-dependent anticancer effects of leptomycin B on lung
adenocarcinoma. Cancer Chemother Pharmacol. 67:1369–1380. 2011.
View Article : Google Scholar : PubMed/NCBI
|
|
2
|
Monroy-Estrada HI, Chirino YI,
Soria-Mercado IE and Sánchez-Rodríguez J: Toxins from the Caribbean
sea anemone Bunodeopsis globulifera increase cisplatin-induced
cytotoxicity of lung adenocarcinoma cells. J Venom Anim Toxins Incl
Trop Dis. 19:122013. View Article : Google Scholar : PubMed/NCBI
|
|
3
|
Ning X, Sun Z, Wang Y, Zhou J, Chen S,
Chen D and Zhang H: Docetaxel plus trans-tracheal injection of
adenoviral-mediated p53 versus docetaxel alone in patients with
previously treated non-small-cell lung cancer. Cancer Gene Ther.
18:444–449. 2011. View Article : Google Scholar : PubMed/NCBI
|
|
4
|
Al-Taweel N, Varghese E, Florea A and
Büsselberg D: Cisplatin (CDDP) triggers cell death of MCF-7 cells
following disruption of intracellular calcium ([Ca (2+)]i)
homeostasis. J Toxicol Sci. 39:765–774. 2014. View Article : Google Scholar : PubMed/NCBI
|
|
5
|
Saha MN, Qiu L and Chang H: Targeting p53
by small molecules in hematological malignancies. J Hematol Oncol.
6:232013. View Article : Google Scholar : PubMed/NCBI
|
|
6
|
Guan YS, Liu Y, Zou Q, He Q, La Z, Yang L
and Hu Y: Adenovirus-mediated wild-type p53 gene transfer in
combination with bronchial arterial infusion for treatment of
advanced non-small-cell lung cancer, one year follow-up. J Zhejiang
Univ Sci B. 10:331–340. 2009. View Article : Google Scholar : PubMed/NCBI
|
|
7
|
Ma JT, Han CB, Zhao JZ, Jing W, Zhou Y,
Huang LT and Zou HW: Synergistic cytotoxic effects of recombinant
human adenovirus p53 and radiation at various time points in A549
lung adenocarcinoma cells. Oncol Lett. 4:529–533. 2012.PubMed/NCBI
|
|
8
|
Pietsch EC, Sykes SM, McMahon SB and
Murphy ME: The p53 family and programmed cell death. Oncogene.
27:6507–6521. 2008. View Article : Google Scholar : PubMed/NCBI
|
|
9
|
Selivanova G: Therapeutic targeting of p53
by small molecules. Semin Cancer Biol. 20:46–56. 2010. View Article : Google Scholar : PubMed/NCBI
|
|
10
|
Rousseau B, Jacquot C, Le Palabe J,
Malleter M, Tomasoni C, Boutard T, Sakanyan V and Roussakis C: TP53
transcription factor for the NEDD9/HEF1/Cas-L gene: Potential
targets in non-small cell lung cancer treatment. Sci Rep.
5:103562015. View Article : Google Scholar : PubMed/NCBI
|
|
11
|
Muller PA and Vousden KH: p53 mutations in
cancer. Nat Cell Biol. 15:2–8. 2013. View
Article : Google Scholar : PubMed/NCBI
|
|
12
|
Liu X, Lin XJ, Wang CP, Yan KK, Zhao LY,
An WX and Liu XD: Association between smoking and p53 mutation in
lung cancer: A meta-analysis. Clin Oncol (R Coll Radiol). 26:18–24.
2014. View Article : Google Scholar : PubMed/NCBI
|
|
13
|
Zhao J, Lu Y and Shen HM: Targeting p53 as
a therapeutic strategy in sensitizing TRAIL-induced apoptosis in
cancer cells. Cancer Lett. 314:8–23. 2012. View Article : Google Scholar : PubMed/NCBI
|
|
14
|
Vaughan CA, Frum R, Pearsall I, Singh S,
Windle B, Yeudall A, Deb SP and Deb S: Allele specific
gain-of-function activity of P53 mutants in lung cancer cells.
Biochem Biophys Res Commun. 428:6–10. 2012. View Article : Google Scholar : PubMed/NCBI
|
|
15
|
Gibbons DL, Byers LA and Kurie JM:
Smoking, p53 mutation, and lung cancer. Mol Cancer Res. 12:3–13.
2014. View Article : Google Scholar : PubMed/NCBI
|
|
16
|
Mattioni M, Soddu S, Prodosmo A, Visca P,
Conti S, Alessandrini G, Facciolo F and Strigari L: Prognostic role
of serum p53 antibodies in lung cancer. BMC cancer. 15:1482015.
View Article : Google Scholar : PubMed/NCBI
|
|
17
|
Machado-Silva A, Perrier S and Bourdon JC:
p53 family members in cancer diagnosis and treatment. Semin Cancer
Biol. 20:57–62. 2010. View Article : Google Scholar : PubMed/NCBI
|
|
18
|
Mogi A and Kuwano H: TP53 mutations in
nonsmall cell lung cancer. J Biomed Biotechnol. 2011:5839292011.
View Article : Google Scholar : PubMed/NCBI
|
|
19
|
Muller PA and Vousden KH: Mutant p53 in
cancer: New functions and therapeutic opportunities. Cancer Cell.
25:304–317. 2014. View Article : Google Scholar : PubMed/NCBI
|
|
20
|
Vassilev LT, Vu BT, Graves B, Carvajal D,
Podlaski F, Filipovic Z, Kong N, Kammlott U, Lukacs C, Klein C, et
al: In vivo activation of the p53 pathway by small-molecule
antagonists of MDM2. Science. 303:844–848. 2004. View Article : Google Scholar : PubMed/NCBI
|
|
21
|
Yu X, Narayanan S, Vazquez A and Carpizo
DR: Small molecule compounds targeting the p53 pathway: Are we
finally making progress? Apoptosis. 19:1055–1068. 2014. View Article : Google Scholar : PubMed/NCBI
|
|
22
|
Yu M, Chen W and Zhang J: p53 gene therapy
for pulmonary metastasis tumor from hepatocellular carcinoma.
Anticancer Drugs. 21:882–884. 2010. View Article : Google Scholar : PubMed/NCBI
|
|
23
|
Duffy MJ, Synnott NC, McGowan PM, Crown J,
O'Connor D and Gallagher WM: p53 as a target for the treatment of
cancer. Cancer Treat Rev. 40:1153–1160. 2014. View Article : Google Scholar : PubMed/NCBI
|
|
24
|
Zhang Y, Zhang Q, Zeng SX, Hao Q and Lu H:
Inauhzin sensitizes p53-dependent cytotoxicity and tumor
suppression of chemotherapeutic agents. Neoplasia. 15:523–534.
2013. View Article : Google Scholar : PubMed/NCBI
|